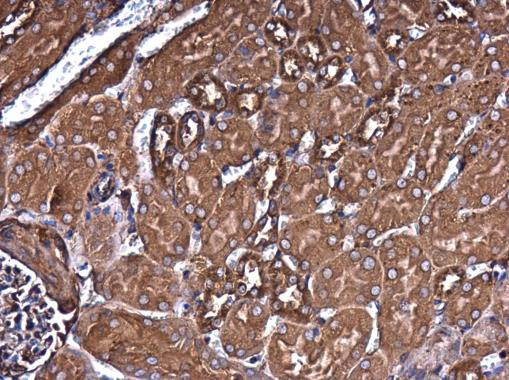
Filamin B Antibody in Immunohistochemistry (Paraffin) (IHC (P))

Search
Invitrogen
Filamin B Monoclonal Antibody (GT1372)
{{$productOrderCtrl.translations['antibody.pdp.commerceCard.promotion.promotions']}}
{{$productOrderCtrl.translations['antibody.pdp.commerceCard.promotion.viewpromo']}}
{{$productOrderCtrl.translations['antibody.pdp.commerceCard.promotion.promocode']}}: {{promo.promoCode}} {{promo.promoTitle}} {{promo.promoDescription}}. {{$productOrderCtrl.translations['antibody.pdp.commerceCard.promotion.learnmore']}}
图: 1 / 4
Filamin B Antibody (MA5-27747) in IHC (P)




产品信息
MA5-27747
种属反应
宿主/亚型
分类
类型
克隆号
抗原
偶联物
形式
浓度
规格
纯化类型
保存液
内含物
保存条件
运输条件
RRID
产品详细信息
Positive Control: HeLa
Predicted Reactivity: Chicken (97%), Bovine (99%)
Store product as a concentrated solution. Centrifuge briefly prior to opening the vial.
靶标信息
FOXK1 is expressed in these cells and regulates cell cycle progression through an interaction with its downstream target the cyclin-dependent kinase inhibitor p21 (CIP). Loss of FOXK1 in mice results in growth retardation and a severe impairment in skeletal muscle regeneration following injury. FOXK1 also shows expression in immature tissues of brain, eye, heart, lung and thymus. It also is predominantly expressed in many malignant tissues, such as tumors of the brain, colon and lymph node.
仅用于科研。不用于诊断过程。未经明确授权不得转售。
篇参考文献 (0)
生物信息学
蛋白别名: ABP-278; ABP-280 homolog; ABP-280-like protein; actin binding protein 278; Actin-binding-like protein; Beta-filamin; Fh1; filamin B, beta; Filamin homolog 1; filamin, beta; Filamin-3; Filamin-B; FilaminB; FLN-B; homolog of ABP-280; Larsen syndrome 1 (autosomal dominant); Thyroid autoantigen; Truncated ABP; Truncated actin-binding protein
基因别名: ABP-278; ABP-280; AL024016; AOI; FH1; FLN-B; FLN1L; FLN3; FLNB; LRS1; SCT; TABP; TAP
UniProt ID: (Human) B2ZZ83, (Mouse) Q80X90
Entrez Gene ID: (Human) 2317, (Mouse) 286940, (Rat) 306204